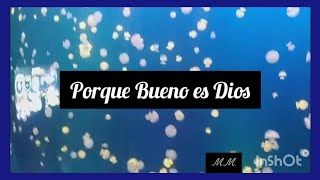

Marí Macareno
Y todos tus hijos serán enseñados por Jehová; y se multiplicará la paz de tus hijos.
Isaías 54:13
Shared 5 months ago
70 views
Shared 1 year ago
65 views
Shared 1 year ago
138 views
Shared 1 year ago
107 views
Shared 1 year ago
2.5K views
Shared 1 year ago
174 views